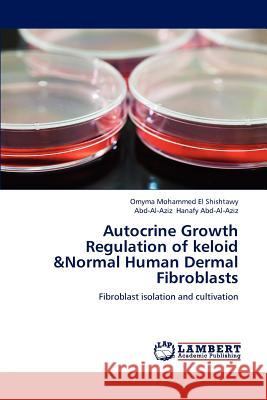
Autocrine Growth Regulation of Keloid &Normal Human Dermal Fibroblasts Omyma Mohammed El Shishtawy, Abd-Al-Aziz Hanafy Abd-Al-Aziz 9783659206351 LAP Lambert Academic Publishing - książka

Autocrine Growth Regulation of Keloid &Normal Human Dermal Fibroblasts » książka
Autocrine Growth Regulation of Keloid &Normal Human Dermal Fibroblasts
ISBN-13: 9783659206351 / Angielski / Miękka / 2012 / 116 str.
Keloid is defined as an abnormal raised, ill-defined scar that grows beyond the boundary of the original site of a skin injury. These are caused by injury to the skin, such as a burn, insect bite, acne, cut, body piercing, or a surgical incision. The treatment of keloid scarring remains one of the most difficult challenges in plastic surgery. The limited success of 1 technique has given rise to numerous treatment protocols. However, keloids still a high recurrence rate. Fibroblasts in keloids have different properties than those seen in normal skin. In this study, we are investigating differences in the autocrine control of both cultured normal human dermal fibroblasts and keloid fibroblasts by studying the effects of fibroblasts conditioned medium at 25 & 50% concentration on P2 cultured fibroblast.